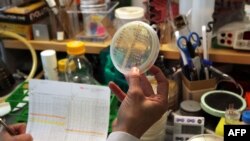

В Стокгольме вручили Нобелевскую премию в области медицины и физиологии. Ее получили американские ученые Элизабет Блэкберн, Кэрол Грэйдер и Джек Шостак - за то, что экспериментально показали, как работают защитные механизмы живой клетки.
Еще с 30-х годов ХХ века биологи знали, что концевые последовательности хромосом играют в жизни клетки важнейшую роль. Они умеют защищать хромосомы от деградации. Уже тогда экспериментами удалось показать: если отваливается концевой участок хромосомы, то она начинает быстро слабеть. Значит, было нечто на концах хромосом, что помогало клетке восстановиться. Но понять, что именно, удалось намного позже, благодаря исследованиям, проведенным в Америке в 1980-е годы. О них рассказывает кандидат биологических наук, сотрудник Института биологии и развития имени Кольцова Алексей Куликов:
- Блэкберн, Шостак и Грейдер в своих работах - занимаясь собственно последовательностями, ферментами, которые взаимодействуют с хромосомами - определили механизмы, с помощью которых хромосома предохраняется.
Американским ученым удалось показать сложнейший процесс, с помощью которого специальный белок-фермент - теломераза - как бы достраивает теломеры (концевые участки хромосом) после деления. Но как часто бывает, многие экспериментальные открытия предсказываются теоретически. В этом случае работа механизма "молекулярных часов" была открыта еще в 1970-е годы российским биологом Алексеем Оловниковым.
- В 1971 году, - напоминает Алексей Куликов, - Алексей Оловников, отталкиваясь от скорости старения хромосом, высказал предположение: существует специализированная ферментативная система, которая в стволовых клетках удлиняет и поддерживает постоянную, нужную длину этих теломерных последовательностей. Тогда как в клетках дифференцированных, которые путем деления получаются из этих стволовых клеток, эта система ослабевает: теломеры и их последовательности укорачиваются. Чем они короче, тем быстрее начинают деградировать хромосомы. Собственно, это и приводит к гибели клеток.
Накануне объявления имен лауреатов Нобелевской премии десять видных американских ученых обратились к Нобелевскому фонду с призывом расширить номинацию по медицине и физиологии и поддержать работы, имеющие прикладное значение. В данном случае открытию механизма старения придают не только фундаментальное значение. С ним связывают большие надежды по преодолению раковых опухолей. Например, возможно ли подавить активность теломеразы - и тем самым лишить раковую клетку возможности восстанавливаться?
- Когда-нибудь – наверное, - полагает Алексей Куликов. - Дело в том, что регуляции этих процессов чрезвычайно сложны. Если в организме появилась некая "взбесившаяся" опухолевая клетка, в которой наблюдается ненормально высокая активность вот этого фермента, то механизм подавления этой активности, в общем-то, пока еще совершенно неясен. Хотя, безусловно, эта активность - один из механизмов бесконечной продолжительности жизни опухолевых клеток.
Еще с 30-х годов ХХ века биологи знали, что концевые последовательности хромосом играют в жизни клетки важнейшую роль. Они умеют защищать хромосомы от деградации. Уже тогда экспериментами удалось показать: если отваливается концевой участок хромосомы, то она начинает быстро слабеть. Значит, было нечто на концах хромосом, что помогало клетке восстановиться. Но понять, что именно, удалось намного позже, благодаря исследованиям, проведенным в Америке в 1980-е годы. О них рассказывает кандидат биологических наук, сотрудник Института биологии и развития имени Кольцова Алексей Куликов:
- Блэкберн, Шостак и Грейдер в своих работах - занимаясь собственно последовательностями, ферментами, которые взаимодействуют с хромосомами - определили механизмы, с помощью которых хромосома предохраняется.
Как часто бывает, многие экспериментальные открытия предсказываются теоретически. В этом случае работа механизма "молекулярных часов" была открыта еще в 1970-е годы российским биологом Алексеем Оловниковым
Американским ученым удалось показать сложнейший процесс, с помощью которого специальный белок-фермент - теломераза - как бы достраивает теломеры (концевые участки хромосом) после деления. Но как часто бывает, многие экспериментальные открытия предсказываются теоретически. В этом случае работа механизма "молекулярных часов" была открыта еще в 1970-е годы российским биологом Алексеем Оловниковым.
- В 1971 году, - напоминает Алексей Куликов, - Алексей Оловников, отталкиваясь от скорости старения хромосом, высказал предположение: существует специализированная ферментативная система, которая в стволовых клетках удлиняет и поддерживает постоянную, нужную длину этих теломерных последовательностей. Тогда как в клетках дифференцированных, которые путем деления получаются из этих стволовых клеток, эта система ослабевает: теломеры и их последовательности укорачиваются. Чем они короче, тем быстрее начинают деградировать хромосомы. Собственно, это и приводит к гибели клеток.
Накануне объявления имен лауреатов Нобелевской премии десять видных американских ученых обратились к Нобелевскому фонду с призывом расширить номинацию по медицине и физиологии и поддержать работы, имеющие прикладное значение. В данном случае открытию механизма старения придают не только фундаментальное значение. С ним связывают большие надежды по преодолению раковых опухолей. Например, возможно ли подавить активность теломеразы - и тем самым лишить раковую клетку возможности восстанавливаться?
- Когда-нибудь – наверное, - полагает Алексей Куликов. - Дело в том, что регуляции этих процессов чрезвычайно сложны. Если в организме появилась некая "взбесившаяся" опухолевая клетка, в которой наблюдается ненормально высокая активность вот этого фермента, то механизм подавления этой активности, в общем-то, пока еще совершенно неясен. Хотя, безусловно, эта активность - один из механизмов бесконечной продолжительности жизни опухолевых клеток.